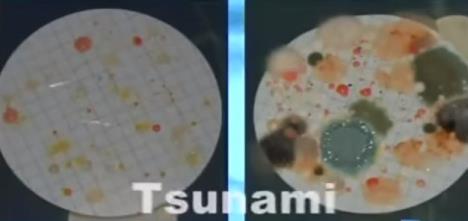
bak.jpg

UŽASNO OTKRIĆE: Posle ovoga vam neće pasti na pamet da naručite led u kafiću (VIDEO)

Svako od nas voli da mu se piće rashladi ledom, pogotovo u letnjim danima. Međutim, da li ste ikada razmišljali koliko se tu krije bakterija?
Posebno je problematičan led koji se poslužuje u ugostiteljskim objektima.
Plesan se može naći i na ledu i to u svim mogućim oblicima, bojama i veličinama. Bakterije se množe brzo i ukoliko se ne primete na vreme, može se stvoriti zaraza.
Čim je površina kontaminirana, bakterije se šire tolikom brzinom da pojedine vrste dupliraju populaciju na svakih 10 minuta.
Stručnjaci su analizirali uzorke leda iz 10 fast-fud restorana u SAD. Utvrđeno je da je na 6 od 10 lokacija led imao viši nivo bakterija nego u ve-ce šoljama! Četiri uzorka su bila toliko zaražena da su mogla da prouzrokuju ozbiljne zdravstvene probleme.
U ovoj studiji analiziran je i ledomat iz jedne bolnice. Pošto mašina za led nije čišćena i servisirana godinama, filteri za vodu nisu bili menjani, pa se stvorilo pogodno tlo za razvoj bakterija. Pronađena je Legionella pneumophila, patogen koji uzrokuje pojavu Legionarske bolesti.
Led je odličan dodatak pićima, ukoliko je čist. Zato je veoma važno čistiti ledomate, kako one u restoranima, kafićima i drugim objektima, tako i one za privatnu upotrebu. Kada vas konobar sledeći put bude pitao želite li led, moraćete dobro da razmislite.
Kurir.rs/Thealternativedaily.com
Foto: Youtube/Printscreen



